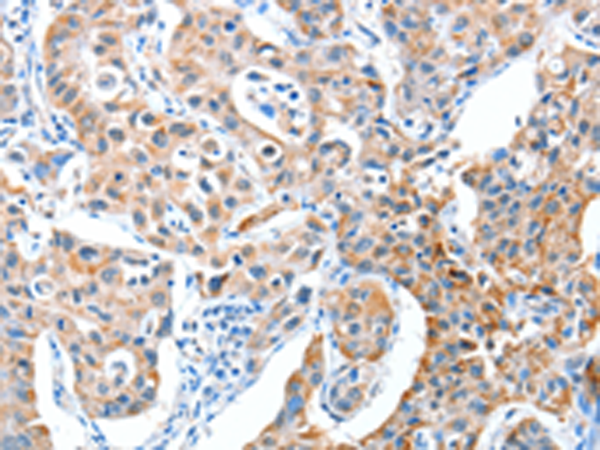
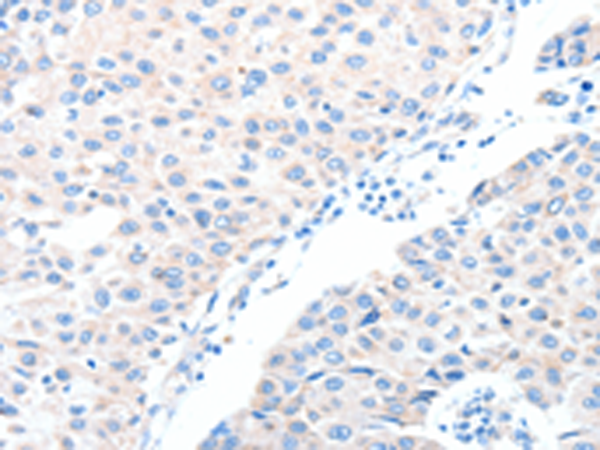

-
分类: 科研抗体货号: P07776别名: CT15; FTNB; PH30; CRYN1; CRYN2; PH-30b; PH30-beta应用: IHC反应种属: Human
-
分类: 科研抗体货号: P07775别名: MDC15应用: WB,IHC反应种属: Human, Mouse, Rat
-
分类: 科研抗体货号: P07790别名:应用: WB,IHC反应种属: Human, Mouse
-
分类: 科研抗体货号: P07774别名: svph4应用: IHC反应种属: Human
-
分类: 科研抗体货号: P07807别名: CBAS2; SRD5B1; 3o5bred应用: WB,IHC反应种属: Human, Mouse, Rat
-
分类: 科研抗体货号: P07788别名: AK应用: WB反应种属: Human, Mouse, Rat
-
分类: 科研抗体货号: P07773别名:应用: WB,IHC反应种属: Human
-
分类: 科研抗体货号: P07806别名: HIS; HSI; ARL1; ARL-1; ALDRLn; AKR1B11; AKR1B12应用: WB,IHC反应种属: Human
-
分类: 科研抗体货号: P07787别名: ADH-2应用: IHC反应种属: Human
-
分类: 科研抗体货号: P07772别名:应用: WB,IHC反应种属: Human

鄂公网安备42018502007531号
鄂公网安备42018502007531号

